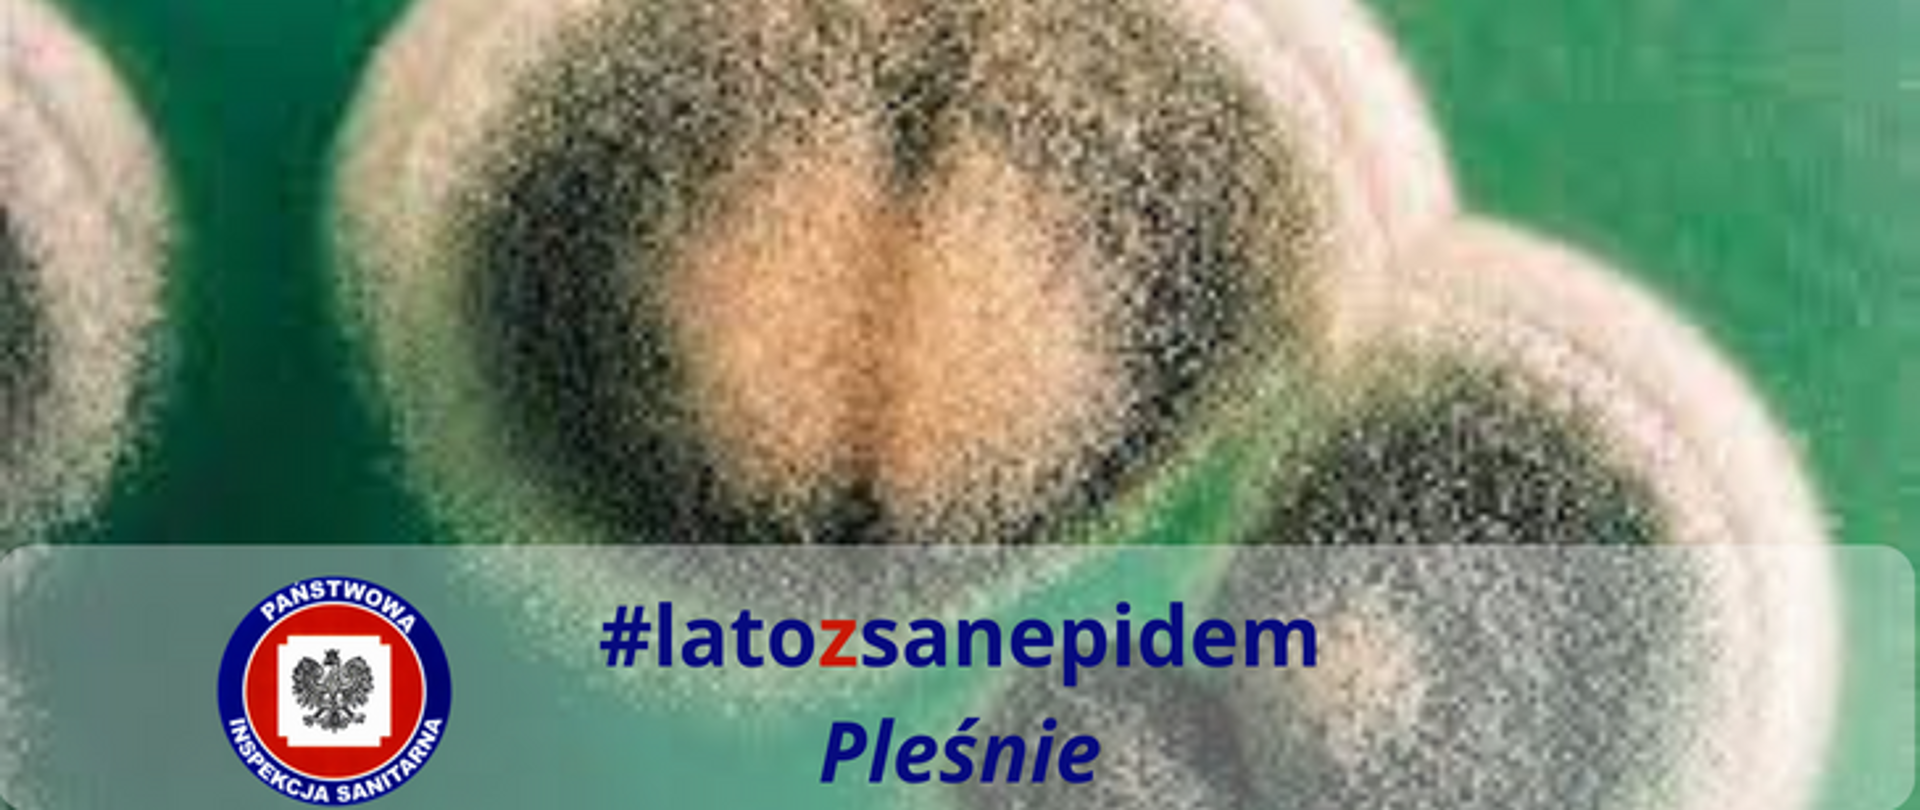
Zdjęcie przedstawiające pleśń #latozsanepidem

#latozsanepidem pleśnie
31.08.2023
Większość ludzi określa pleśń jako szary lub biały nalot, który pojawia się na artykułach spożywczych, takich jak chleb, owoce czy warzywa. Nie jest to błędem, ponieważ osadzenie się go na żywności jest znakiem, że jedzenie nie nadaje się do spożycia. Czym w takim razie są pleśnie?
Pleśnie to grzyby należące do saprofitów czyli organizmów czerpiących pożywienie z martwej materii organicznej. Charakteryzują się nitkowatymi strzępkami i szarym, białym lub zielonym nalotem. Występuje wiele rodzajów pleśni – zależnie od miejsca, w którym się znajdują oraz sposobu w jaki działają na organizm.
Wśród gatunków groźnych dla człowieka wyróżnić można:
- buławinkę czerwoną
- fusarium
- penicillium
- aspergillus
Grzyby te wytwarzają mikotoksyny czyli trujące związki, wykazujące negatywne działanie na organizm człowieka. Pleśnie zazwyczaj osadzą się na: warzywach, owocach, płatkach zbożowych, orzechach,
nasionach, mięsie i przetworach mlecznych. Do najbardziej niebezpiecznych rodzajów toksyn zalicza się: patulinę, zearalenon, fumonizyny, ochratoksynę A i deoksyniwalenol. Mikotoksyny mają wielokierunkowy, niezwykle wyniszczający wpływ na organizmy żywe, w tym na człowieka. Wykazują one działania:
- kancerogenne – przyczyniające się do powstawania i rozwoju chorób nowotworowych,
- hepatotoksyczne – uszkadzające wątrobę,
- kardiotoksyczne – zaburzające prawidłowe funkcjonowanie układu krwionośnego
- pulmotoksyczne – powodujące obrzęki płuc, a w efekcie choroby układu oddechowego
- dermatotoksyczne – przyczyniające się do uszkodzenia powierzchni skóry i błon śluzowych
- neurotoksyczne – wywierające negatywny wpływ na funkcjonowanie układu nerwowego
- teratogenne – uszkadzające płód (w przypadku kobiet w ciąży)
Jak więc zachować się gdy pleśń dostanie się do jedzenia?
Większość osób usuwa część pokrytą pleśnią z jedzenia, a resztę konsumuje. Jest to bardzo niebezpieczne, gdyż strzępki grzybni przerastają głęboko i mikotoksyny zazwyczaj znajdują się
w całym produkcie. Nie wolno spożywać takiej żywności – należy ją od razu wyrzucić.
Zmniejszenie ryzyka rozwoju pleśni możemy osiągnąć poprzez zwrócenie większej uwagi na wybierane artykuły spożywcze podczas zakupów. Nie powinniśmy kupować owoców jagodowych: malin, truskawek czy borówek w dużych ilościach, a po zakupie przechowywać w odpowiednich warunkach. Najlepsze do tego będą miejsca suche i chłodne. Warto sprawdzać wygląd i zapach żywności, a w przypadku produktów zapakowanych datę przydatności do spożycia.
Pleśnie to nie tylko nalot na żywności. Pleśnie mogą również być obecne w naszych domach, np. na ścianach, podłodze, w uszczelkach okien czy nawet na zasłonach. Codzienne przebywanie w pomieszczeniach gdzie występują tego typu zanieczyszczenia wywierają negatywny wpływ na układ oddechowy. Regularne wdychanie pleśni prowadzi do bardziej lub mniej poważnych schorzeń. Należą do nich głównie: katar; kaszel; nieżyt nosa; duszności; zwiększone, bardziej intensywne reakcje alergiczne i nasilenie objawów astmy. Na większe ryzyko zatrucia pleśnią poprzez wdychanie narażeni ludzie po 50. roku życia, niemowlęta i dzieci oraz osoby, cierpiące na choroby układu oddechowego. W przypadku gdy zaobserwujemy długo utrzymujące się wyżej wymienione objawy warto przyjrzeć się czy w domu nie jest obecna pleśń, a następnie ją usunąć.